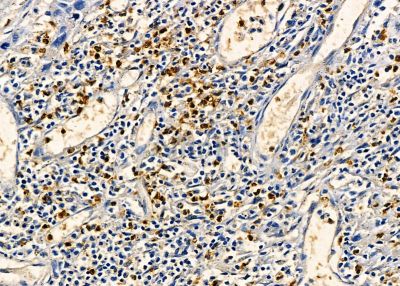
RBM24 Antibody - DF13843 at 1/100 staining human esophageal cancer by IHC-P.
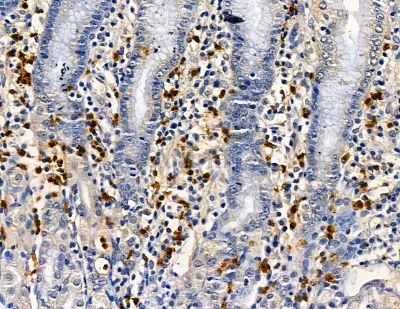
RBM24 Antibody - DF13843 at 1/100 staining human pancreatic cancer and para-carcinoma tissue by IHC-P.

RBM24 Antibody - #DF13843
Related Downloads
Protocols
Product Info
*The optimal dilutions should be determined by the end user. For optimal experimental results, antibody reuse is not recommended.
*Tips:
WB: For western blot detection of denatured protein samples. IHC: For immunohistochemical detection of paraffin sections (IHC-p) or frozen sections (IHC-f) of tissue samples. IF/ICC: For immunofluorescence detection of cell samples. ELISA(peptide): For ELISA detection of antigenic peptide.
Fold/Unfold
dJ259A10.1; FLJ26355; FLJ30829; FLJ37697; RBM 24; rbm24; RBM24_HUMAN; RNA binding motif protein 24; RNA binding protein 24; RNA binding region (RNP1 RRM) containing 6; RNA binding region containing protein 6; RNA-binding motif protein 24; RNA-binding protein 24; RNA-binding region-containing protein 6; RNPC6;
Immunogens
A synthesized peptide derived from Human RBM24.
Expressed in fetal and adult heart and skeletal muscles (PubMed:22345307, PubMed:25313962).
- Q9BX46 RBM24_HUMAN:
- Protein BLAST With
- NCBI/
- ExPASy/
- Uniprot
MHTTQKDTTYTKIFVGGLPYHTTDASLRKYFEVFGEIEEAVVITDRQTGKSRGYGFVTMADRAAAERACKDPNPIIDGRKANVNLAYLGAKPRIMQPGFAFGVQQLHPALIQRPFGIPAHYVYPQAFVQPGVVIPHVQPTAAAASTTPYIDYTGAAYAQYSAAAAAAAAAAAYDQYPYAASPAAAGYVTAGGYGYAVQQPITAAAPGTAAAAAAAAAAAAAFGQYQPQQLQTDRMQ
Research Backgrounds
Multifunctional RNA-binding protein involved in the regulation of pre-mRNA splicing, mRNA stability and mRNA translation important for cell fate decision and differentiation. Plays a major role in pre-mRNA alternative splicing regulation. Mediates preferentially muscle-specific exon inclusion in numerous mRNAs important for striated cardiac and skeletal muscle cell differentiation. Binds to intronic splicing enhancer (ISE) composed of stretches of GU-rich motifs localized in flanking intron of exon that will be included by alternative splicing (By similarity). Involved in embryonic stem cell (ESC) transition to cardiac cell differentiation by promoting pre-mRNA alternative splicing events of several pluripotency and/or differentiation genes. Plays a role in the regulation of mRNA stability. Binds to 3'-untranslated region (UTR) AU-rich elements in target transcripts, such as CDKN1A and MYOG, leading to maintain their stabilities. Involved in myogenic differentiation by regulating MYOG levels. Binds to multiple regions in the mRNA 3'-UTR of TP63 isoform 2, hence inducing its destabilization. Promotes also the destabilization of the CHRM2 mRNA via its binding to a region in the coding sequence. Plays a role in the regulation of mRNA translation. Mediates repression of p53/TP53 mRNA translation through its binding to U-rich element in the 3'-UTR, hence preventing EIF4E from binding to p53/TP53 mRNA and translation initiation. Binds to a huge amount of mRNAs. Required for embryonic heart development, sarcomer and M-band formation in striated muscles (By similarity).
Nucleus. Cytoplasm.
Expressed in fetal and adult heart and skeletal muscles.
The RRM domain is necessary for mRNA stability and mRNA translation regulation (PubMed:24356969, PubMed:29358667).
Restrictive clause
Affinity Biosciences tests all products strictly. Citations are provided as a resource for additional applications that have not been validated by Affinity Biosciences. Please choose the appropriate format for each application and consult Materials and Methods sections for additional details about the use of any product in these publications.
For Research Use Only.
Not for use in diagnostic or therapeutic procedures. Not for resale. Not for distribution without written consent. Affinity Biosciences will not be held responsible for patent infringement or other violations that may occur with the use of our products. Affinity Biosciences, Affinity Biosciences Logo and all other trademarks are the property of Affinity Biosciences LTD.